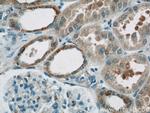
HEATR2 Antibody in Immunohistochemistry (Paraffin) (IHC (P))
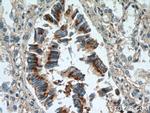
HEATR2 Antibody in Immunohistochemistry (Paraffin) (IHC (P))

Search
Proteintech
HEATR2 Polyclonal Antibody
{{$productOrderCtrl.translations['antibody.pdp.commerceCard.promotion.promotions']}}
{{$productOrderCtrl.translations['antibody.pdp.commerceCard.promotion.viewpromo']}}
{{$productOrderCtrl.translations['antibody.pdp.commerceCard.promotion.promocode']}}: {{promo.promoCode}} {{promo.promoTitle}} {{promo.promoDescription}}. {{$productOrderCtrl.translations['antibody.pdp.commerceCard.promotion.learnmore']}}
产品信息
24578-1-AP
种属反应
已发表种属
宿主/亚型
分类
类型
抗原
偶联物
形式
浓度
规格
纯化类型
保存液
内含物
保存条件
运输条件
产品详细信息
Immunogen sequence: NLQWHAGRT AAAIRTAAVS CLWALTSSEV LSAEQIRDVQ ETLMPQVLTT LEEDSKMTRL ISCRIINTFL KTSGGMTDPE KLIRIYPELL KRLDDVSNDV RMAAASTLVT WLQCVKGANA KSYYQSSVQY LYRELLVHLD DPERAIQDAI (661-809 aa encoded by BC047240)
靶标信息
The protein encoded by this gene is essential for the preassembly or stability of axonemal dynein arms, and is found only in organisms with motile cilia and flagella. Mutations in this gene are associated with primary ciliary dyskinesia-18, a disorder characterized by abnormalities of motile cilia. Alternatively spliced transcript variants have been found for this gene.
仅用于科研。不用于诊断过程。未经明确授权不得转售。
生物信息学
蛋白别名: dynein assembly factor 5, axonemal; Dynein axonemal assembly factor 5; HEAT repeat containing 2; HEAT repeat-containing protein 2; unnamed protein product
基因别名: CILD18; DNAAF5; HEATR2
UniProt ID: (Human) Q86Y56
Entrez Gene ID: (Human) 54919, (Rat) 304332